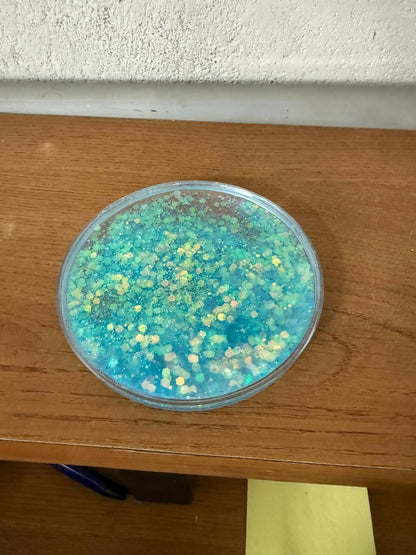
Glitter Resin Tea Coaster Round Sparkle Cup Coaster for Table Decor (MUG NOT INCLUDED)

Glitter Resin Tea Coaster Round Sparkle Cup Coaster for Table Decor (MUG NOT INCLUDED)
Glitter Resin Tea Coaster Round Sparkle Cup Coaster for Table Decor (MUG NOT INCLUDED)
Couldn't load pickup availability
Order Today
Order Ready
Delivered
Share
Translation missing: en.general.accessibility.share_on_facebook
Translation missing: en.general.accessibility.share_on_x
Translation missing: en.general.accessibility.share_on_linkedin
Translation missing: en.general.accessibility.share_on_pinterest
Translation missing: en.general.accessibility.share_on_whatsapp
Description
Description
Enhance your table décor with this Glitter Resin Tea Coaster featuring a beautiful sparkling finish.
Designed to protect surfaces from heat, stains and scratches, this round coaster combines utility with style.
Crafted from premium quality resin, it is durable, lightweight and easy to maintain. The glitter effect gives a classy and eye-catching look, making it perfect for everyday use at home, office or cafés. A stylish addition to your drinkware collection and an excellent gifting option.
🔹 KEY FEATURES (Bullet Points)
• Premium Glitter Resin Design – Shiny glitter finish adds an elegant and modern touch to your table
• Heat Resistant Coaster – Protects table surface from hot tea, coffee & mugs
• Smooth & Durable Finish – Made from high-quality resin, strong, long-lasting and easy to clean
• Perfect Size for Cups & Mugs – Suitable for tea cups, coffee mugs, glasses & small bowls
• Ideal Gift Option – Great for housewarming, birthdays, festivals & return gifts
tea coaster resin, glitter cup coaster, coffee mug coaster, round tea coaster, table coaster set, resin coaster for cups, decorative tea coaster, drink coaster for table, heat resistant coaster, sparkle coaster
Country Of Origin :- China
GST :- 18%

Customers who bought this item also bought
Size thoda chhota laga but fine hai
Glitter coaster bahut stylish aur elegant lagta hai
Recently Viewed Products
Categories
- Just Arrived
- Best Seller
Shop By
Health & Personal Care
Home & Kitchen
Home Improvement
Jewellery
Office Products
Electronics
Toys & Games
More
Offers
Help & More
Help
Contact Us
Care@deodap.com
- Choosing a selection results in a full page refresh.
- Opens in a new window.























































































































































































































































